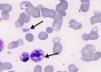
fig0010

A middle-aged woman was admitted to the Teaching Hospital of the Universidade de São Paulo, Brazil with pneumonia symptoms. She had fever, cough and weakness associated with epigastric pain. An abdominal computed tomography scan showed extensive adenopathy with an enlarged spleen. Serology for HIV was positive and yeast forms were observed in the peripheral blood smear (Figures 1 and 2).
Diagnosis of histoplasmosis is made by the detection of Histoplasma capsulatum in sputum, blood or liquor but it is common to observe negative results due to technical constraints wherein a reduced number of fungal forms are found in samples.1 Imaging, diagnostic scanning tests and biopsy of target organs are important to differentiate from tuberculosis, sarcoidosis or metastatic carcinoma and lymphoma and usually the culture of biological samples and serological assays are performed to confirm the diagnosis.1,2 However, a blood smear is important to establish the diagnosis of disseminated histoplasmosis and, after in vitro contamination is excluded, the presence of both free and intracellular H. capsulatum should be reported.
Conflicts of interestThe authors declare no conflicts of interest.